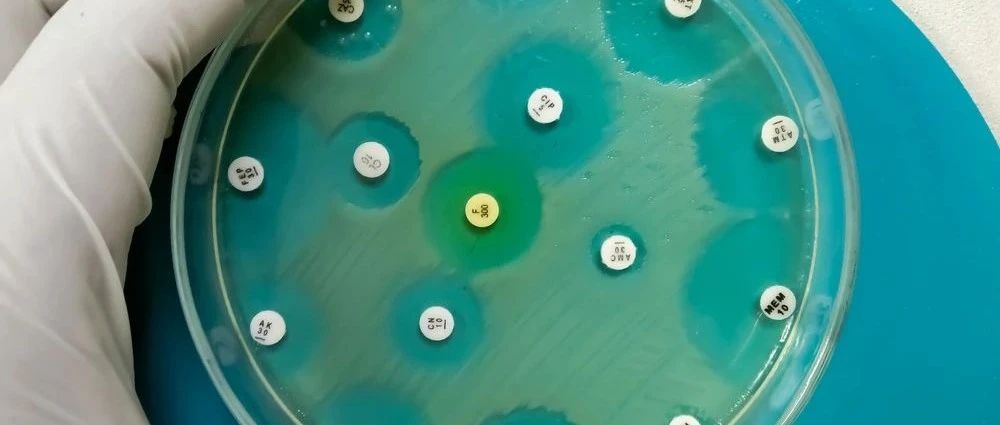

「美罗」or「亚胺」,碳青霉烯类药物如何合理选择?一文理清
*仅供医学专业人士阅读参考碳青霉烯类药物如何选择,看完这篇就懂了! 碳青霉烯类属于β-内酰胺抗菌药物,其抗菌谱广、杀菌活性强、临床用途广泛;是临床治疗重症、混合感染、耐药菌的一线药物。研究表明革兰阴性菌所致的感染占65.7%-73%[1],明显高于革兰阳性菌。 碳青霉烯类对革兰阴性菌具有强大的抗菌作用,特别是对多重耐药(MDR)、泛耐药革兰阴性菌(XDR-GNB)所致的感染,碳青霉烯受到广泛推崇。例如,对于产超广谱β-内酰胺酶(ESBLs)和头孢菌素酶(Ampc)的肠杆菌(大肠埃希菌、肺炎克雷伯菌等)所致的肺部感染,碳青霉烯的临床疗效满意。...
美罗培南与治疗药物监测,这些问题值得了解!
*仅供医学专业人士参考阅读治疗药物监测能给美罗培南的临床使用带来诸多益处。 美罗培南的特征与应用场景美罗培南为人工合成的广谱碳青霉烯类抗生素,是非典型的β-内酰胺类抗菌药物,常用于住院患者严重感染和院内感染的治疗。其通过与青霉素结合蛋白(penicillin-binding protein,PBP)紧密结合,阻碍细菌细胞壁的合成,使细菌迅速肿胀、溶解发挥作用,除金属β-内酰胺酶以外,美罗培南对大多数β-内酰胺酶的水解作用具有较强的稳定性。其对革兰阴性和阳性菌、需氧菌、厌氧菌皆有良好抗菌活性。美罗培南是时间依赖性抗菌药物,主要经肾排泄,蛋白结合率为约2%。...